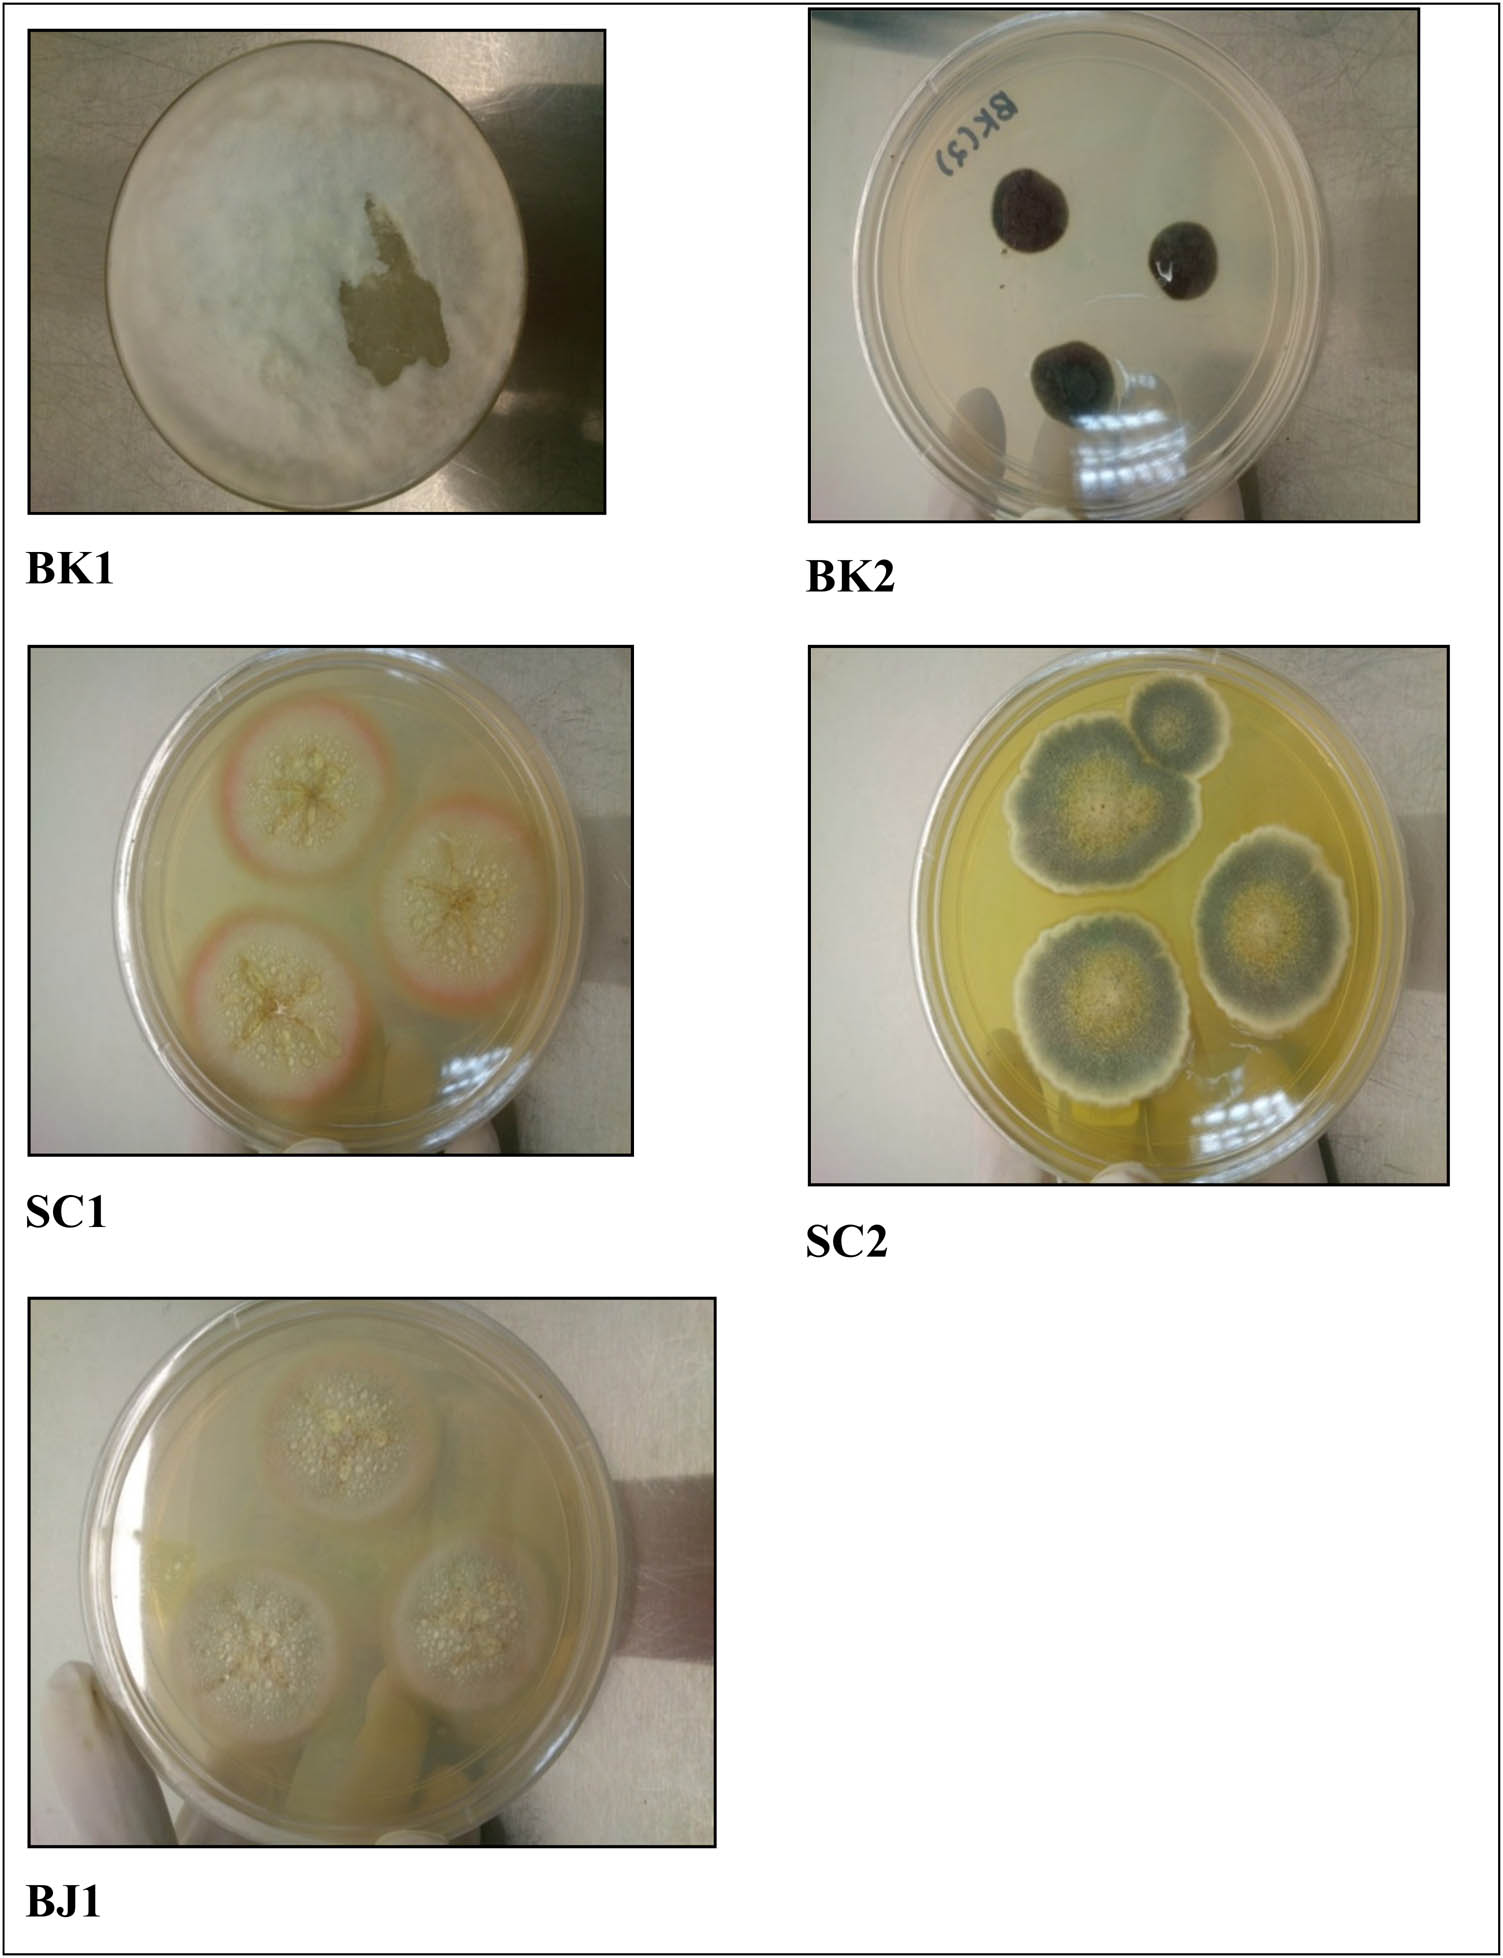

The aim of this study is to address the growing concern about microplastics in the ocean and their potential harm to human health through ingestion. The MPs issue is largely a result of the increasing demand for electronic devices and their components. To tackle this challenge, the research aimed to develop a green polymer electrolyte that used glycerol as a plasticizing agent to improve ionic conductivity. The polymer host included chitosan and polyvinyl alcohol and was composed of sodium acetate. To evaluate the performance of the polymer electrolyte, various analytical techniques were used, including impedance and electrochemical studies. The ionic conductivity of 7.56 × 10 −5 S·cm −1 was recorded. The dielectric property study confirmed the ionic conduction process in the system and revealed the existence of non-Debye type relaxation, as indicated by asymmetric peaks of tan δ spectra. The alternating conductivity exhibits three distinguished regions. The polymer electrolyte was discovered to be electrochemically stable up to 2.33 V and capable of storing energy as a non-Faradaic electrochemical double-layer capacitor (EDLC). The cyclic voltammetry pattern is a leaf like shape. The EDLC was able to be charged and discharged up to 1 V, and it showed cyclability and could be used in low-voltage applications.
Contents
- Research Articles
-
Open AccessIsolation, screening and optimization of alkaliphilic cellulolytic fungi for production of cellulaseFebruary 1, 2024
-
Open AccessBiosynthesis of silver nanoparticles on yellow phosphorus slag and its application in organic coatingsFebruary 9, 2024
-
Open AccessSilicotungstic acid supported on Bi-based MOF-derived metal oxide for photodegradation of organic dyesFebruary 12, 2024
-
February 14, 2024
-
February 21, 2024
-
April 9, 2024
-
May 8, 2024
-
May 21, 2024
-
May 31, 2024
-
June 14, 2024
-
June 26, 2024
-
July 10, 2024
-
Open AccessHighly efficient oil–water separation using superhydrophobic cellulose aerogels derived from corn strawAugust 23, 2024
-
September 2, 2024
-
Open AccessGreen synthesis of silver nanoparticles from Bauhinia variegata and their biological applicationsSeptember 12, 2024
-
Open AccessSynthesis and optimization of long-chain fatty acids via the oxidation of long-chain fatty alcoholsSeptember 16, 2024
-
Open AccessEminent Red Sea water hydrogen generation via a Pb(ii)-iodide/poly(1H-pyrrole) nanocomposite photocathodeSeptember 19, 2024
-
September 30, 2024
-
October 1, 2024
-
Open AccessDetection of morphine and data processing using surface plasmon resonance imaging sensorOctober 19, 2024
-
October 29, 2024
-
Open AccessUse of a humidity adsorbent derived from cockleshell waste in Thai fried fish crackers (Keropok)November 9, 2024
-
Open AccessSynthesis of motexafin gadolinium: A promising radiosensitizer and imaging agent for cancer therapyNovember 15, 2024
-
Open AccessPhysical intrinsic characteristics of spheroidal particles in coal gasification fine slagNovember 29, 2024
-
Open AccessZein polymer nanocarrier for Ocimum basilicum var. purpurascens extract: Potential biomedical useDecember 5, 2024
-
Open AccessBi2O3–BiOCl/poly-m-methyl aniline nanocomposite thin film for broad-spectrum light-sensingDecember 31, 2024
- Review Articles
-
February 21, 2024
-
July 5, 2024
-
September 19, 2024
- Special Issue: Emerging green nanomaterials for sustainable waste management and biomedical applications
- Special Issue: New insights into nanopythotechnology: current trends and future prospects
-
May 29, 2024
- Special Issue: Composites and green composites
- Retraction